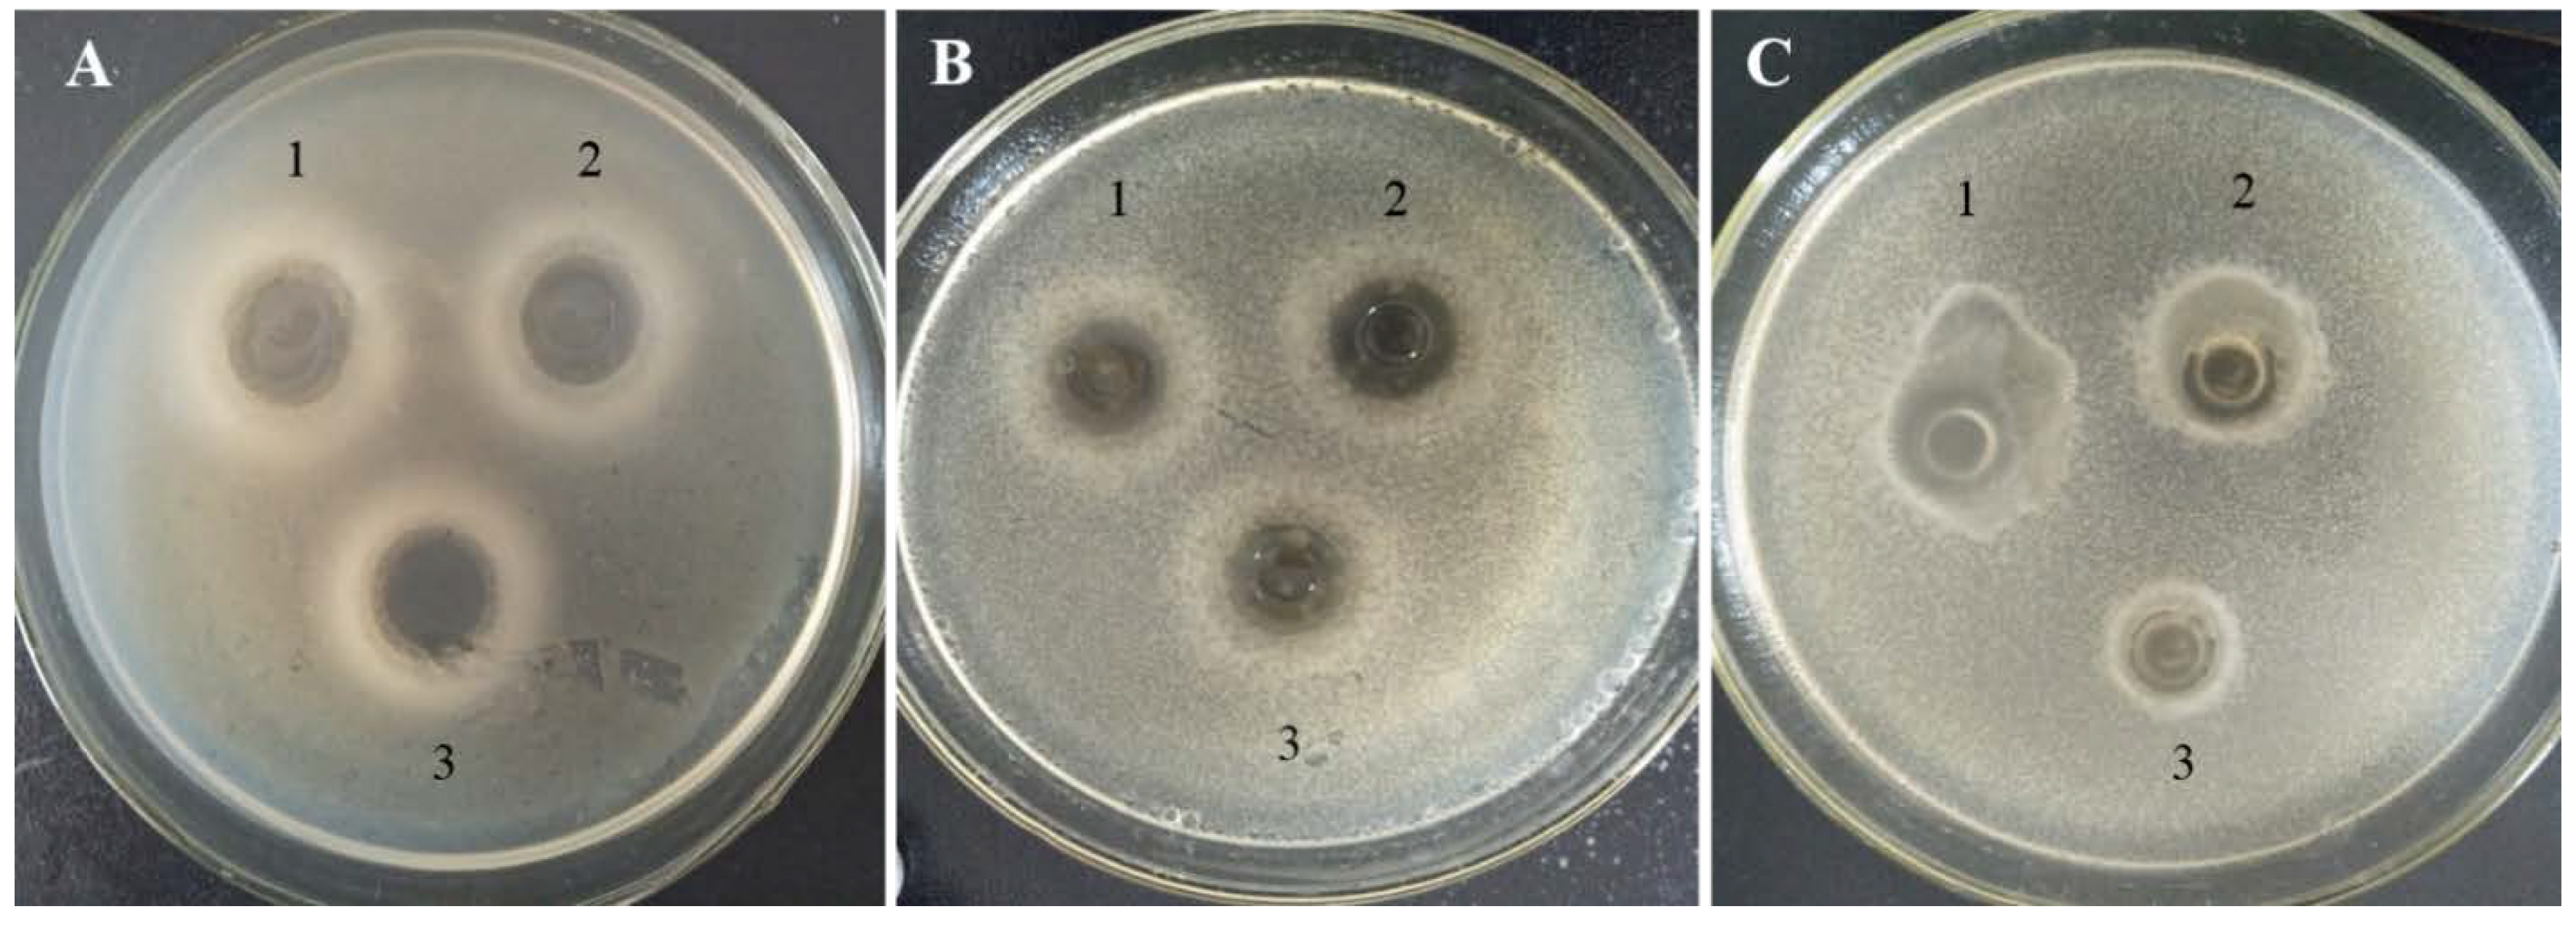

Effect of Novel Bacteriocinogenic Lactobacillus fermentum BZ532 on Microbiological Shelf-Life and Physicochemical and Organoleptic Properties of Fresh Home-Made Bozai
Abstract
:1. Introduction
2. Materials and Methods
2.1. Bacterial Strains and Culture Conditions
2.2. Fresh Bozai Production
2.3. Microbiological Analysis
2.3.1. Total Viable Count (TVC) and LAB Enumeration
2.3.2. Co-Culturing of L. fermentum BZ532 with Pathogenic Bacteria during Bozai Production
2.3.3. In Situ Production of Bacteriocin Antimicrobial Compounds
2.4. Physicochemical Evaluation of Bozai
2.4.1. Titratable Acidity
2.4.2. pH
2.4.3. Total Protein Content
2.5. Organoleptic Evaluation
2.6. Statistical Analysis
3. Results and Discussion
3.1. Changes in TVC and L. fermentum BZ532 Enumeration during Bozai Storage
3.2. Co-Culturing of L. fermentum BZ532 with Pathogenic Bacteria during Bozai Production
3.3. In Situ Bacteriocin Activities in Bozai during Storage
3.4. Changes in Physicochemical Parameters of Bozai during Storage
3.5. Changes in Organoleptic Properties of Bozai during Storage
4. Conclusions
Author Contributions
Funding
Institutional Review Board Statement
Informed Consent Statement
Data Availability Statement
Conflicts of Interest
References
- Yildirim, Z.; Bilgin, H.; Isleroglu, H.; Tokatli, K.; Sahingil, D.; Yildirim, M. Enterocin HZ produced by a wild Enterococcus faecium strain isolated from a traditional, starter-free pickled cheese. J. Dairy Res. 2014, 81, 164. [Google Scholar] [CrossRef]
- De Vuyst, L.; Callewaert, R.; Pot, B. Characterization of the antagonistic activity of Lactobacillus amylovorus DCE 471 and large scale isolation of its bacteriocin amylovorin L471. Syst. Appl. Microbiol. 1996, 19, 9–20. [Google Scholar] [CrossRef]
- Kang, M.-S.; Lim, H.-S.; Oh, J.-S.; Lim, Y.-j.; Wuertz-Kozak, K.; Harro, J.M.; Shirtliff, M.E.; Achermann, Y. Antimicrobial activity of Lactobacillus salivarius and Lactobacillus fermentum against Staphylococcus aureus. Pathog. Dis. 2017, 75, ftx009. [Google Scholar] [CrossRef]
- Asan-Ozusaglam, M.; Gunyakti, A. Lactobacillus fermentum strains from human breast milk with probiotic properties and cholesterol-lowering effects. Food Sci. Biotechnol. 2019, 28, 501–509. [Google Scholar] [CrossRef] [PubMed]
- Abdelgadir, W.S.; Hamad, S.H.; Møller, P.L.; Jakobsen, M. Characterisation of the dominant microbiota of Sudanese fermented milk Rob. Int. Dairy J. 2001, 11, 63–70. [Google Scholar] [CrossRef]
- de Souza Rodrigues, J.Z.; Passos, M.R.; de Macêdo Neres, N.S.; Almeida, R.S.; Pita, L.S.; Santos, I.A.; Silveira, P.H.S.; Reis, M.M.; Santos, I.P.; Ricardo, L.d.O.N. Antimicrobial activity of Lactobacillus fermentum TcUESC01 against Streptococcus mutans UA159. Microb. Pathog. 2020, 142, 104063. [Google Scholar] [CrossRef]
- Park, J.-H.; Lee, Y.; Moon, E.; SEOK, S.-H.; BAEK, M.-W.; LEE, H.-Y.; KIM, D.-J.; KIM, C.-H.; Park, J.-H. Safety assessment of Lactobacillus fermentum PL9005, a potential probiotic lactic acid bacterium, in mice. J. Microbiol. Biotechnol. 2005, 15, 603–608. [Google Scholar]
- Gardiner, G.E.; Heinemann, C.; Baroja, M.L.; Bruce, A.W.; Beuerman, D.; Madrenas, J.n.; Reid, G. Oral administration of the probiotic combination Lactobacillus rhamnosus GR-1 and L. fermentum RC-14 for human intestinal applications. Int. Dairy J. 2002, 12, 191–196. [Google Scholar] [CrossRef]
- Sadeghi, A. In vitro Assessment of Some Probiotic Properties of Lactobacillus fermentum Isolated from Pickled Garlic. J. Food Qual. Hazards Control 2016, 3, 67–72. [Google Scholar]
- Anukam, K.; Reid, G. Lactobacillus plantarum and Lactobacillus fermentum with probiotic potentials isolated from the vagina of healthy Nigerian women. Res. J. Microbiol. 2007, 2, 81–87. [Google Scholar]
- Kaur, B.; Balgir, P.; Mittu, B.; Chauhan, A.; Kumar, B. Purification and physicochemical characterization of anti-Gardnerella vaginalis bacteriocin HV6b produced by Lactobacillus fermentum isolate from human vaginal ecosystem. Am. J. Biochem. Mol. Biol. 2013, 3, 91–100. [Google Scholar] [CrossRef] [Green Version]
- Fuochi, V.; Li Volti, G.; Furneri, P.M. Probiotic properties of Lactobacillus fermentum strains isolated from human oral samples and description of their antibacterial activity. Curr. Pharm. Biotechnol. 2017, 18, 138–149. [Google Scholar] [CrossRef] [PubMed]
- EFSA Panel on Biological Hazards; Koutsoumanis, K.; Allende, A.; Alvarez-Ordóñez, A.; Bolton, D.; Bover-Cid, S.; Chemaly, M.; Davies, R.; De Cesare, A.; Hilbert, F. Update of the list of QPS-recommended biological agents intentionally added to food or feed as notified to EFSA 12: Suitability of taxonomic units notified to EFSA until March 2020. EFSA J. 2020, 18, e06174. [Google Scholar] [PubMed]
- FAO/WHO. Evaluation of Certain Food Additives: Seventy-Ninth Report of the Joint FAO/WHO Expert Committee on Food Additives; World Health Organization: Geneva, Switzerland, 2015; Volume 79. [Google Scholar]
- Castellano, P.; Pérez Ibarreche, M.; Blanco Massani, M.; Fontana, C.; Vignolo, G.M. Strategies for pathogen biocontrol using lactic acid bacteria and their metabolites: A focus on meat ecosystems and industrial environments. Microorganisms 2017, 5, 38. [Google Scholar] [CrossRef] [Green Version]
- Gálvez, A.; Abriouel, H.; López, R.L.; Omar, N.B. Bacteriocin-based strategies for food biopreservation. Int. J. Food Microbiol. 2007, 120, 51–70. [Google Scholar] [CrossRef]
- Mokoena, M.P. Lactic acid bacteria and their bacteriocins: Classification, biosynthesis and applications against uropathogens: A mini-review. Molecules 2017, 22, 1255. [Google Scholar] [CrossRef] [PubMed]
- Gharsallaoui, A.; Oulahal, N.; Joly, C.; Degraeve, P. Nisin as a food preservative: Part 1: Physicochemical properties, antimicrobial activity, and main uses. Crit. Rev. Food Sci. Nutr. 2016, 56, 1262–1274. [Google Scholar] [CrossRef]
- Guinane, C.; Cotter, P.; Hill, C.; Ross, R. Microbial solutions to microbial problems; lactococcal bacteriocins for the control of undesirable biota in food. J. Appl. Microbiol. 2005, 98, 1316–1325. [Google Scholar] [CrossRef] [PubMed]
- Punyauppa-path, S.; Phumkhachorn, P.; Rattanachaikunsopon, P. Nisin: Production and mechanism of antimicrobial action. Int. J. Curr. Res. Rev. 2015, 7, 47. [Google Scholar]
- Shahidi, F.; Chandrasekara, A. Millet grain phenolics and their role in disease risk reduction and health promotion: A review. J. Funct. Foods 2013, 5, 570–581. [Google Scholar] [CrossRef]
- Chandra, D.; Chandra, S.; Sharma, A. Review of Finger millet (Eleusine coracana (L.) Gaertn): A power house of health benefiting nutrients. Food Sci. Hum. Wellness 2016, 5, 149–155. [Google Scholar] [CrossRef] [Green Version]
- Taylor, J.R. Millets: Their unique nutritional and health-promoting attributes. In Gluten-Free Ancient Grains; Elsevier: Amsterdam, The Netherlands, 2017; pp. 55–103. [Google Scholar]
- Saleh, A.S.; Zhang, Q.; Chen, J.; Shen, Q. Millet grains: Nutritional quality, processing, and potential health benefits. Compr. Rev. Food Sci. Food Saf. 2013, 12, 281–295. [Google Scholar] [CrossRef]
- Hancioğlu, Ö.; Karapinar, M. Microflora of Boza, a traditional fermented Turkish beverage. Int. J. Food Microbiol. 1997, 35, 271–274. [Google Scholar] [CrossRef]
- Zorba, M.; Hancioglu, O.; Genc, M.; Karapinar, M.; Ova, G. The use of starter cultures in the fermentation of boza, a traditional Turkish beverage. Process Biochem. 2003, 38, 1405–1411. [Google Scholar] [CrossRef]
- Rasheed, H.A.; Tuoheti, T.; Zhang, Y.; Azi, F.; Tekliye, M.; Dong, M. Purification and partial characterization of a novel bacteriocin produced by bacteriocinogenic Lactobacillus fermentum BZ532 isolated from Chinese fermented cereal beverage (Bozai). LWT 2020, 124, 109113. [Google Scholar] [CrossRef]
- Todorov, S.; Nyati, H.; Meincken, M.; Dicks, L. Partial characterization of bacteriocin AMA-K, produced by Lactobacillus plantarum AMA-K isolated from naturally fermented milk from Zimbabwe. Food Control 2007, 18, 656–664. [Google Scholar] [CrossRef]
- Todorov, S.; Dicks, L. Pediocin ST18, an anti-listerial bacteriocin produced by Pediococcus pentosaceus ST18 isolated from boza, a traditional cereal beverage from Bulgaria. Process Biochem. 2005, 40, 365–370. [Google Scholar] [CrossRef]
- de Castilho, N.P.A.; Todorov, S.D.; Oliveira, L.L.; dos Santos Bersot, L.; Nero, L.A. Inhibition of Listeria monocytogenes in fresh sausage by bacteriocinogenic Lactobacillus curvatus UFV-NPAC1 and its semi-purified bacteriocin. LWT 2020, 118, 108757. [Google Scholar] [CrossRef]
- Cuniffe, P. Official Methods of Analysis of the Association of Official Analytical Chemists, 16th ed.; AOAC International: Washington, DC, USA, 1995. [Google Scholar]
- AACC. Approved Methods of the American Association of Cereal Chemists, 10th ed.; American Association of Cereal Chemists: St. Paul, MN, USA, 2000; Volume 1. [Google Scholar]
- AOAC. Official Methods of Analysis, 13th ed.; AOAC International: Washington, DC, USA, 1980; Volume 13. [Google Scholar]
- Arslan, S.; Durak, A.N.; Erbas, M.; Tanriverdi, E.; Gulcan, U. Determination of microbiological and chemical properties of probiotic boza and its consumer acceptability. J. Am. Coll. Nutr. 2015, 34, 56–64. [Google Scholar] [CrossRef]
- Chen, C.; Rui, X.; Lu, Z.; Li, W.; Dong, M. Enhanced shelf-life of tofu by using bacteriocinogenic Weissella hellenica D1501 as bioprotective cultures. Food Control 2014, 46, 203–209. [Google Scholar] [CrossRef]
- Osimani, A.; Garofalo, C.; Aquilanti, L.; Milanović, V.; Clementi, F. Unpasteurised commercial boza as a source of microbial diversity. Int. J. Food Microbiol. 2015, 194, 62–70. [Google Scholar] [CrossRef] [PubMed]
- Pateiro, M.; Vargas, F.C.; Chincha, A.A.; Sant’Ana, A.S.; Strozzi, I.; Rocchetti, G.; Barba, F.J.; Domínguez, R.; Lucini, L.; do Amaral Sobral, P.J. Guarana seed extracts as a useful strategy to extend the shelf life of pork patties: UHPLC-ESI/QTOF phenolic profile and impact on microbial inactivation, lipid and protein oxidation and antioxidant capacity. Food Res. Int. 2018, 114, 55–63. [Google Scholar] [CrossRef] [PubMed]
- Öztürk, İ.; Karaman, S.; Törnük, F.; Sağdiç, O. Physicochemical and rheological characteristics of alcohol free probiotic boza produced using Lactobacillus casei Shirota: Estimation of apparent viscosity of boza using non-linear modeling techniques. Turk. J. Agric. For. 2013, 37, 475–487. [Google Scholar] [CrossRef]
- Barbosa, M.; Todorov, S.; Belguesmia, Y.; Choiset, Y.; Rabesona, H.; Ivanova, I.; Chobert, J.M.; Haertlé, T.; Franco, B. Purification and characterization of the bacteriocin produced by L actobacillus sakei MBS a1 isolated from B razilian salami. J. Appl. Microbiol. 2014, 116, 1195–1208. [Google Scholar] [CrossRef] [PubMed]
- Schillinger, U.; Becker, B.; Vignolo, G.; Holzapfel, W. Efficacy of nisin in combination with protective cultures against Listeria monocytogenes Scott A in tofu. Int. J. Food Microbiol. 2001, 71, 159–168. [Google Scholar] [CrossRef]
- Cotter, P.D.; Hill, C.; Ross, R.P. Bacteriocins: Developing innate immunity for food. Nat. Rev. Microbiol. 2005, 3, 777–788. [Google Scholar] [CrossRef]
- Aspri, M.; O’Connor, P.M.; Field, D.; Cotter, P.D.; Ross, P.; Hill, C.; Papademas, P. Application of bacteriocin-producing Enterococcus faecium isolated from donkey milk, in the bio-control of Listeria monocytogenes in fresh whey cheese. Int. Dairy J. 2017, 73, 1–9. [Google Scholar] [CrossRef]
- Kivanc, M.; Yilmaz, M.; Çakir, E. Isolation and identification of lactic acid bacteria from boza, and their microbial activity against several reporter strains. Turk. J. Biol. 2011, 35, 313–324. [Google Scholar]
- Russo, P.; de Chiara, M.L.V.; Capozzi, V.; Arena, M.P.; Amodio, M.L.; Rascón, A.; Dueñas, M.T.; López, P.; Spano, G. Lactobacillus plantarum strains for multifunctional oat-based foods. Lwt-Food Sci. Technol. 2016, 68, 288–294. [Google Scholar] [CrossRef] [Green Version]
- Helland, M.H.; Wicklund, T.; Narvhus, J.A. Growth and metabolism of selected strains of probiotic bacteria, in maize porridge with added malted barley. Int. J. Food Microbiol. 2004, 91, 305–313. [Google Scholar] [CrossRef]
- Kockova, M.; Valík, Ľ. Development of new cereal-, pseudocereal-, and cereal-leguminous-based probiotic foods. Czech J. Food Sci. 2014, 32, 391–397. [Google Scholar] [CrossRef]
- Arslan-Tontul, S.; Erbas, M. Co-Culture probiotic fermentation of protein-enriched cereal medium (Boza). J. Am. Coll. Nutr. 2020, 39, 72–81. [Google Scholar] [CrossRef]
- do Amaral Santos, C.C.A.; da Silva Libeck, B.; Schwan, R.F. Co-culture fermentation of peanut-soy milk for the development of a novel functional beverage. Int. J. Food Microbiol. 2014, 186, 32–41. [Google Scholar] [CrossRef] [PubMed]
- Cotter, P.D.; Hill, C. Surviving the acid test: Responses of gram-positive bacteria to low pH. Microbiol. Mol. Biol. Rev. 2003, 67, 429–453. [Google Scholar] [CrossRef] [PubMed] [Green Version]

| Indicator Strains | Antimicrobial Activities 1 | |||||
|---|---|---|---|---|---|---|
| 24 h | 36 h | 48 h | ||||
| BZ-C | BZ-LF | BZ-C | BZ-LF | BZ-C | BZ-LF | |
| Staphylococcus aureus | 1.66 ± 0.21 b | 3.32 ± 0.08 a | 1.81 ± 0.17 b | 4.85 ± 0.10 a | 1.93 ± 0.15 b | 5.54 ± 0.13 a |
| Escherichia coli k-12 | 1.84 ± 0.15 b | 3.64 ± 0.06 a | 1.98 ± 0.17 b | 5.36 ± 0.13 a | 2.09 ± 0.22 b | 5.64 ± 0.09 a |
| Salmonella sp. D104 | 1.02 ± 0.16 a | 0 ± 0 b | 1.11 ± 0.13 a | 0 ± 0 b | 1.26 ± 0.21 a | 0 ± 0 b |
| Parameters | Treatments | Storage Time (Days) | |||
|---|---|---|---|---|---|
| 1 | 3 | 5 | 7 | ||
| pH | BZ-C | 5.75 ± 0.13 a | 5.47 ± 0.08 a | 5.22 ± 0.09 a | 5.11 ± 0.11 a |
| BZ-Lf | 4.51 ± 0.11 b | 3.85 ± 0.10 b | 3.25 ± 0.06 b | 3.11 ± 0.06 b | |
| Total acidity (%) | BZ-C | 0.89 ± 0.08 b | 1.36 ± 0.04 b | 1.70 ± 0.08 b | 1.89 ± 0.07 b |
| BZ-Lf | 2.37 ± 0.13 a | 3.14 ± 0.04 a | 3.69 ± 0.14 a | 3.88 ± 0.07 a | |
| Protein (%) | BZ-C | 3.26 ± 0.41 b | 2.82 ± 0.38 b | 3.15 ± 0.31 b | 2.69 ± 0.21 b |
| BZ-Lf | 3.07 ± 0.51 a | 2.99 ± 0.23 a | 3.18 ± 0.33 a | 2.87 ± 0.26 a | |
| Parameters | Treatments | Storage Time (Days) | |||
|---|---|---|---|---|---|
| 1 | 3 | 5 | 7 | ||
| Color | BZ-C | 5.76 ± 0.40 b | 4.88 ± 0.32 b | 5.1 ± 0.17 b | 4.66 ± 0.23 b |
| BZ-Lf | 6.55 ± 0.23 a | 5.70 ± 0.20 a | 5.93 ± 0.40 a | 5.53 ± 0.50 a | |
| Odour | BZ-C | 4.26 ± 0.46 b | 4.56 ± 0.40 b | 4.66 ± 0.57 b | 5.66 ± 0.57 b |
| BZ-Lf | 6.33 ± 0.57 a | 5.56 ± 0.51 a | 6.50 ± 0.5 a | 6.83 ± 0.76 a | |
| Mouthfeel | BZ-C | 5.26 ± 0.64 b | 5.13 ± 0.80 b | 4.86 ± 0.80 b | 4.56 ± 0.51 b |
| BZ-Lf | 6.63 ± 0.47 a | 5.86 ± 0.51 a | 6.46 ± 0.45 a | 5.66 ± 0.57 a | |
| Overall acceptability | BZ-C | 5.60 ± 0.36 b | 5.5 ± 0.86 b | 5.5 ± 0.5 b | 5.20 ± 0.34 b |
| BZ-Lf | 6.66 ± 0.76 a | 6.06 ± 0.4 a | 6.0 ± 0.30 a | 5.93 ± 0.40 a | |
Publisher’s Note: MDPI stays neutral with regard to jurisdictional claims in published maps and institutional affiliations. |
© 2021 by the authors. Licensee MDPI, Basel, Switzerland. This article is an open access article distributed under the terms and conditions of the Creative Commons Attribution (CC BY) license (https://creativecommons.org/licenses/by/4.0/).
Share and Cite
Rasheed, H.A.; Tuoheti, T.; Li, Z.; Tekliye, M.; Zhang, Y.; Dong, M. Effect of Novel Bacteriocinogenic Lactobacillus fermentum BZ532 on Microbiological Shelf-Life and Physicochemical and Organoleptic Properties of Fresh Home-Made Bozai. Foods 2021, 10, 2120. https://doi.org/10.3390/foods10092120
Rasheed HA, Tuoheti T, Li Z, Tekliye M, Zhang Y, Dong M. Effect of Novel Bacteriocinogenic Lactobacillus fermentum BZ532 on Microbiological Shelf-Life and Physicochemical and Organoleptic Properties of Fresh Home-Made Bozai. Foods. 2021; 10(9):2120. https://doi.org/10.3390/foods10092120
Chicago/Turabian StyleRasheed, Hafiz Abdul, Tuhanguli Tuoheti, Zhiyu Li, Mekonen Tekliye, Yongzhu Zhang, and Mingsheng Dong. 2021. "Effect of Novel Bacteriocinogenic Lactobacillus fermentum BZ532 on Microbiological Shelf-Life and Physicochemical and Organoleptic Properties of Fresh Home-Made Bozai" Foods 10, no. 9: 2120. https://doi.org/10.3390/foods10092120
APA StyleRasheed, H. A., Tuoheti, T., Li, Z., Tekliye, M., Zhang, Y., & Dong, M. (2021). Effect of Novel Bacteriocinogenic Lactobacillus fermentum BZ532 on Microbiological Shelf-Life and Physicochemical and Organoleptic Properties of Fresh Home-Made Bozai. Foods, 10(9), 2120. https://doi.org/10.3390/foods10092120

